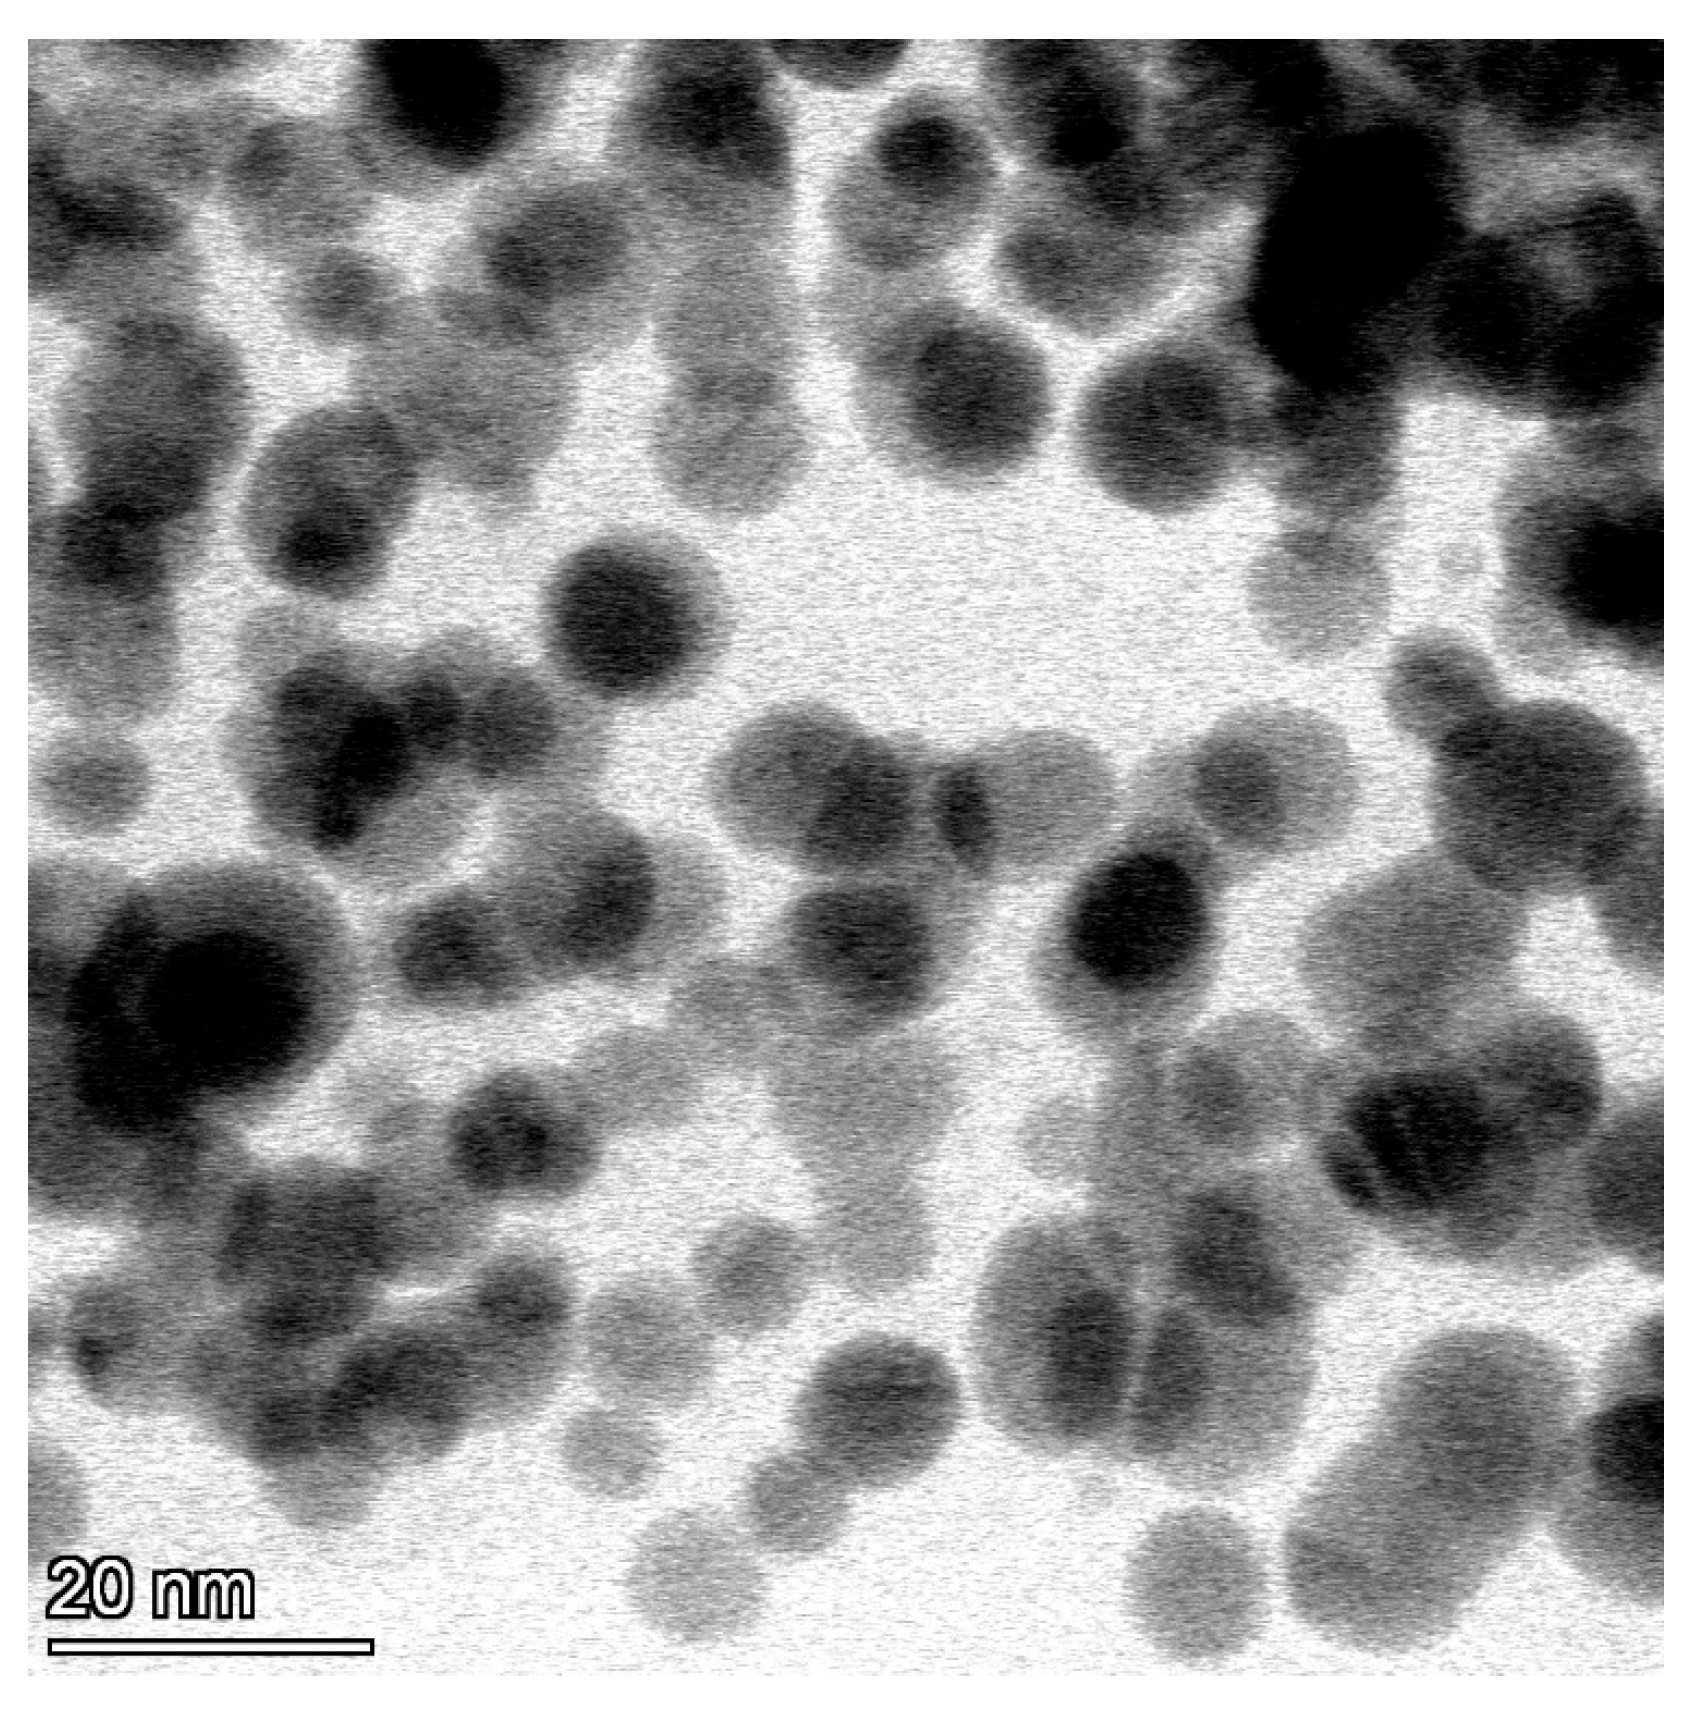
Viruses 15 01689 g001 Viruses 15 01689 g001

Silver Nanoparticles Proved to Be Efficient Antivirals In Vitro against Three Highly Pathogenic Fish Viruses
Abstract
1. Introduction
2. Materials and Methods
2.1. Cells and Viruses
2.2. AgNP Synthesis
2.3. AgNP Characterization
2.4. Cytotoxicity Assay
2.5. In Vitro Assays for Silver Nanoparticles and Virus Interaction Studies
2.6. Virus Pre-Treatment Assay
2.7. Cell Pre-Treatment Assay
2.8. Cell Post-Treatment Assay
2.9. Quantitative PCRs
2.10. Statistical Analysis
3. Results
3.1. AgNP Characterisation
3.2. Cytotoxicity Assays
3.3. In Vitro Assays
4. Discussion
Author Contributions
Funding
Conflicts of Interest
References
- Shaalan, M.; Saleh, M.; El-Mahdy, M.; El-Matbouli, M. Recent progress in applications of nanoparticles in fish medicine: A review. Nanomed. Nanotechnol. Biol. Med. 2016, 12, 701–710. [Google Scholar] [CrossRef] [PubMed]
- Lang, C.; Mission, E.G.; Fuaad, A.A.; Shaalan, M. Nanoparticle tools to improve and advance precision practices in the Agrifoods Sector towards sustainability-A review. J. Clean. Prod. 2021, 293, 126063. [Google Scholar] [CrossRef]
- Kobayashi, R.K.; Dhakal, S.; Nakazato, G. The Use of Nanoparticles in the Diagnosis and Therapy of Infectious Disease in Animals. Front. Vet. Sci. 2021, 8, 1602. [Google Scholar] [CrossRef] [PubMed]
- Abu-Elala, N.M.; Shaalan, M.; Ali, S.E.; Younis, N.A. Immune responses and protective efficacy of diet supplementation with selenium nanoparticles against cadmium toxicity in Oreochromis niloticus. Aquac. Res. 2021, 52, 3677–3686. [Google Scholar] [CrossRef]
- Mahboub, H.H.; Shahin, K.; Mahmoud, S.M.; Altohamy, D.E.; Husseiny, W.A.; Mansour, D.A.; Shalaby, S.I.; Gaballa, M.M.; Shaalan, M.; Alkafafy, M.; et al. Silica nanoparticles are novel aqueous additive mitigating heavy metals toxicity and improving the health of African catfish, Clarias gariepinus. Aquat. Toxicol. 2022, 249, 106238. [Google Scholar] [CrossRef]
- Saleh, M.; Essawy, E.; Shaalan, M.; Osman, S.; Ahmed, F.; El-Matbouli, M. Therapeutic Intervention with Dietary Chitosan Nanoparticles Alleviates Fish Pathological and Molecular Systemic Inflammatory Responses against Infections. Mar. Drugs 2022, 20, 425. [Google Scholar] [CrossRef]
- Matharu, R.K.; Ciric, L.; Edirisinghe, M. Nanocomposites: Suitable alternatives as antimicrobial agents. Nanotechnology 2018, 29, 282001. [Google Scholar] [CrossRef]
- Elgendy, M.Y.; Shaalan, M.; Abdelsalam, M.; Eissa, A.E.; El-Adawy, M.M.; Seida, A.A. Antibacterial activity of silver nanoparticles against antibiotic-resistant Aeromonas veronii infections in Nile tilapia, Oreochromis niloticus (L.), in vitro and in vivo assay. Aquac. Res. 2022, 53, 901–920. [Google Scholar] [CrossRef]
- Kalelkar, P.P.; Riddick, M.; García, A.J. Biomaterial-based antimicrobial therapies for the treatment of bacterial infections. Nat. Rev. Mater. 2022, 7, 39–54. [Google Scholar] [CrossRef]
- Lara, H.H.; Ayala-Nuñez, N.V.; Ixtepan-Turrent, L.; Rodriguez-Padilla, C. Mode of antiviral action of silver nanoparticles against HIV-1. J. Nanobiotechnol. 2010, 8, 1. [Google Scholar] [CrossRef]
- Vijayakumar, S.; Ganesan, S. Gold nanoparticles as an HIV entry inhibitor. Curr. HIV Res. 2012, 10, 643–646. [Google Scholar] [CrossRef] [PubMed]
- Elechiguerra, J.L.; Burt, J.L.; Morones, J.R.; Camacho-Bragado, A.; Gao, X.; Lara, H.H.; Yacaman, M.J. Interaction of silver nanoparticles with HIV-1. J. Nanobiotechnol. 2005, 3, 6. [Google Scholar] [CrossRef] [PubMed]
- Sun, L.; Singh, A.K.; Vig, K.; Pillai, S.R.; Singh, S.R. Silver nanoparticles inhibit replication of respiratory syncytial virus. J. Biomed. Nanotechnol. 2008, 4, 149–158. [Google Scholar] [CrossRef]
- Morris, D.; Ansar, M.; Speshock, J.; Ivanciuc, T.; Qu, Y.; Casola, A.; Garofalo, R.P. Antiviral and immunomodulatory activity of silver nanoparticles in experimental RSV infection. Viruses 2019, 11, 732. [Google Scholar] [CrossRef]
- Lu, L.; Sun, R.W.Y.; Chen, R.; Hui, C.K.; Ho, C.M.; Luk, J.M.; Lau, G.K.; Che, C.M. Silver nanoparticles inhibit hepatitis B virus replication. Antivir. Ther. 2008, 13, 253–262. [Google Scholar] [CrossRef]
- Rogers, J.V.; Parkinson, C.V.; Choi, Y.W.; Speshock, J.L.; Hussain, S.M. A preliminary assessment of silver nanoparticle inhibition of monkeypox virus plaque formation. Nanoscale Res. Lett. 2008, 3, 129–133. [Google Scholar] [CrossRef]
- Trefry, J.C.; Wooley, D.P. Silver nanoparticles inhibit vaccinia virus infection by preventing viral entry through a macropinocytosis-dependent mechanism. J. Biomed. Nanotechnol. 2013, 9, 1624–1635. [Google Scholar] [CrossRef] [PubMed]
- Gaikwad, S.; Ingle, A.; Gade, A.; Rai, M.; Falanga, A.; Incoronato, N.; Russo, L.; Galdiero, S.; Galdiero, M. Antiviral activity of mycosynthesized silver nanoparticles against herpes simplex virus and human parainfluenza virus type 3. Int. J. Nanomed. 2013, 8, 4303–4314. [Google Scholar]
- Akbarzadeh, A.; Kafshdooz, L.; Razban, Z.; Dastranj Tbrizi, A.; Rasoulpour, S.; Khalilov, R.; Kavetskyy, T.; Saghfi, S.; Nasibova, A.N.; Kaamyabi, S.; et al. An overview application of silver nanoparticles in inhibition of herpes simplex virus. Artif. Cells Nanomed. Biotechnol. 2018, 46, 263–267. [Google Scholar] [CrossRef]
- Mehrbod, P.; Motamed, N.; Tabatabaeian, M.; Soleymani, E.R.; Amini, E.; Shahidi, M.; Kheyri, M.T. In Vitro Antiviral Effect of “Nanosilver” on Influenza Virus. DARU 2009, 17, 88–93. [Google Scholar]
- Mori, Y.; Ono, T.; Miyahira, Y.; Nguyen, V.Q.; Matsui, T.; Ishihara, M. Antiviral activity of silver nanoparticle/chitosan composites against H1N1 influenza A virus. Nanoscale Res. Lett. 2013, 8, 96. [Google Scholar] [CrossRef] [PubMed]
- Kumar, R.; Nayak, M.; Sahoo, G.C.; Pandey, K.; Sarkar, M.C.; Ansari, Y.; Das, V.N.; Topno, R.K.; Madhukar, M.; Das, P. Iron oxide nanoparticles based antiviral activity of H1N1 influenza A virus. J. Infect. Chemother. 2019, 25, 325–329. [Google Scholar] [CrossRef] [PubMed]
- Ghaffari, H.; Tavakoli, A.; Moradi, A.; Tabarraei, A.; Bokharaei-Salim, F.; Zahmatkeshan, M.; Farahmand, M.; Javanmard, D.; Kiani, S.J.; Esghaei, M.; et al. Inhibition of H1N1 influenza virus infection by zinc oxide nanoparticles: Another emerging application of nanomedicine. J. Biomed. Sci. 2019, 26, 70. [Google Scholar] [CrossRef]
- Shionoiri, N.; Sato, T.; Fujimori, Y.; Nakayama, T.; Nemoto, M.; Matsunaga, T.; Tanaka, T. Investigation of the antiviral properties of copper iodide nanoparticles against feline calicivirus. J. Biosci. Bioeng. 2012, 113, 580–586. [Google Scholar] [CrossRef]
- Matharu, R.K.; Cheong, Y.K.; Ren, G.; Edirisinghe, M.; Ciric, L. Exploiting the antiviral potential of intermetallic nanoparticles. Emergent Mater. 2021, 5, 1251–1260. [Google Scholar] [CrossRef]
- De Silva, C.; Nawawi, N.M.; Abd Karim, M.M.; Abd Gani, S.; Masarudin, M.J.; Gunasekaran, B.; Ahmad, S.A. The Mechanistic Action of Biosynthesised Silver Nanoparticles and Its Application in Aquaculture and Livestock Industries. Animals 2021, 11, 97. [Google Scholar] [CrossRef] [PubMed]
- Sarkheil, M.; Sourinejad, I.; Mirbakhsh, M.; Kordestani, D.; Johari, S. Application of silver nanoparticles immobilized on TEPA-Den-SiO2 as water filter media for bacterial disinfection in culture of Penaeid shrimp larvae. Aquac. Eng. 2016, 74, 17–29. [Google Scholar] [CrossRef]
- Pradeep, T.; Anshup. Noble metal nanoparticles for water purification: A critical review. Thin Solid Film 2009, 517, 6441–6478. [Google Scholar] [CrossRef]
- Vaseeharan, B.; Ramasamy, P.; Chen, J. Antibacterial activity of silver nanoparticles (AgNps) synthesized by tea leaf extracts against pathogenic Vibrio harveyi and its protective efficacy on juvenile Feneropenaeus indicus. Lett. Appl. Microbiol. 2010, 50, 352–356. [Google Scholar] [CrossRef]
- Shaalan, M.; Sellyei, B.; El-Matbouli, M.; Székely, C. Efficacy of silver nanoparticles to control flavobacteriosis caused by Flavobacterium johnsoniae in common carp Cyprinus carpio. Dis. Aquat. Organ. 2020, 137, 175–183. [Google Scholar] [CrossRef]
- Pelgrift, R.; Friedman, A. Nanotechnology as a therapeutic tool to combat microbial resistance. Adv. Drug Deliv. Rev. 2013, 65, 1803–1815. [Google Scholar] [CrossRef] [PubMed]
- Durán, N.; Durán, M.; De Jesus, M.B.; Seabra, A.B.; Fávaro, W.J.; Nakazato, G. Silver nanoparticles: A new view on mechanistic aspects on antimicrobial activity. Nanomed. Nanotechnol. Biol. Med. 2016, 12, 789–799. [Google Scholar] [CrossRef] [PubMed]
- Salleh, A.; Naomi, R.; Utami, N.D.; Mohammad, A.W.; Mahmoudi, E.; Mustafa, N.; Fauzi, M.B. The potential of silver nanoparticles for antiviral and antibacterial applications: A mechanism of action. Nanomaterials 2020, 10, 1566. [Google Scholar] [CrossRef]
- Pryshchepa, O.; Pomastowski, P.; Buszewski, B. Silver nanoparticles: Synthesis, investigation techniques, and properties. Adv. Colloid Interface Sci. 2020, 284, 102246. [Google Scholar] [CrossRef]
- Ochoa-Meza, A.; Alvarez-Sanchez, A.; Romo-Quinonez, C.; Barraza, A.; Magallon-Barajas, F.; Chavez-Sanchez, A.; Garcia-Ramos, J.; Toledano-Magana, Y.; Bogdanchikova, N.; Pestryakov, A.; et al. Silver nanoparticles enhance survival of white spot syndrome virus infected Penaeus vannamei shrimps by activation of its immunological system. Fish Shellfish Immunol. 2019, 84, 1083–1089. [Google Scholar] [CrossRef]
- Romo-Quinonez, C.; Alvarez-Sanchez, A.; Alvarez-Ruiz, P.; Chavez-Sanchez, M.; Bogdanchikova, N.; Pestryakov, A.; Mejia-Ruiz, C. Evaluation of a new Argovit as an antiviral agent included in feed to protect the shrimp Litopenaeus vannamei against White Spot Syndrome Virus infection. PeerJ 2020, 8, e8446. [Google Scholar] [CrossRef] [PubMed]
- Qin, N.; Hemmes, P.; Mitchen, K. Characterization of the Silver Nanoparticles in the Sovereign Silver® and Argentyn 23®, Bio-Active Silver Hydrosol™ Products. Int. J. Nanomed. 2022, 17, 983–986. [Google Scholar] [CrossRef]
- Walker, P.; Freitas-Astua, J.; Bejerman, N.; Blasdell, K.; Breyta, R.; Dietzgen, R.; Fooks, A.; Kondo, H.; Kurath, G.; Kuzmin, I.; et al. ICTV Virus Taxonomy Profile: Rhabdoviridae 2022. J. Gen. Virol. 2022, 103, 001689. [Google Scholar] [CrossRef] [PubMed]
- Fijan, N.; Petrinec, Z.; Sulimanovic, D.; Zwillenberg, L. Isolation of the viral causative agent from the acute form of infectious dropsy of carp. Vet. Arch. 1971, 41, 125–138. [Google Scholar]
- Wolf, K. Fish Viruses and Fish Viral Diseases; Comstock Publishing Associates; Cornell University Press: Ithaca, NY, USA, 1988. [Google Scholar]
- Chinchar, V.G.; Hick, P.; Ince, I.A.; Jancovich, J.K.; Marschang, R.; Qin, Q.; Subramaniam, K.; Waltzek, T.B.; Whittington, R.; Williams, T.; et al. ICTV Virus Taxonomy Profile: Iridoviridae. J. Gen. Virol. 2017, 98, 890–891. [Google Scholar] [CrossRef]
- Ahne, W.; Schlotfeldt, H.; Thomsen, I. Fish Viruses—Isolation of an icosahedral cytoplasmic deoxyribovirus from sheatfish (Silurus glanis). Zent. Vet. B 1989, 36, 333–336. [Google Scholar] [CrossRef] [PubMed]
- Leimbach, S.; Schütze, H.; Bergmann, S. Susceptibility of European Sheatfish Silurus Glanis to a Panel of Ranaviruses. J. Appl. Ichthyol 2014, 30, 93–101. [Google Scholar] [CrossRef]
- Pozet, F.; Morand, M.; Moussa, A.; Torhy, C.; Dekinkelin, P. Isolation and preliminary characterization of a pathogenic icosahedral deoxyribovirus from the catfish Ictalurus melas. Dis. Aquat. Org. 1992, 14, 35–42. [Google Scholar] [CrossRef]
- Bigarre, L.; Cabon, J.; Baud, M.; Pozet, F.; Castric, J. Ranaviruses associated with high mortalities in catfish in France. Bull. Eur. Assoc. Fish Pathol. 2008, 28, 163–168. [Google Scholar]
- Fehér, E.; Doszpoly, A.; Horváth, B.; Marton, S.; Forró, B.; Farkas, S.L.; Bányai, K.; Juhász, T. Whole genome sequencing and phylogenetic characterization of brown bullhead (Ameiurus nebulosus) origin ranavirus strains from independent disease outbreaks. Infect. Genet. Evol. 2016, 45, 402–407. [Google Scholar] [CrossRef] [PubMed]
- Borzym, E.; Karpińska, T.A.; Reichert, M. Outbreak of ranavirus infection in sheatfish, Silurus glanis (L.), in Poland. Pol. J. Vet. Sci. 2015, 18, 607–611. [Google Scholar] [CrossRef] [PubMed][Green Version]
- Abonyi, F.; Varga, A.; Sellyei, B.; Eszterbauer, E.; Doszpoly, A. Juvenile Wels Catfish (Silurus glanis) Display Age-Related Mortality to European Catfish Virus (ECV) under Experimental Conditions. Viruses 2022, 14, 1832. [Google Scholar] [CrossRef]
- Juhasz, T.; Woynarovichne, L.; Csaba, G.; Farkas, L.; Dan, A. Isolation of ranavirus causing mass mortality in brown bullheads (Ameiurus nebulosus) in Hungary. Magy. Allatorv. Lapja 2013, 135, 763–768. [Google Scholar]
- Davison, A.J.; Eberle, R.; Ehlers, B.; Hayward, G.S.; McGeoch, D.J.; Minson, A.C.; Pellett, P.E.; Roizman, B.; Studdert, M.J.; Thiry, E. The order Herpesvirales. Arch. Virol. 2009, 154, 171–177. [Google Scholar] [CrossRef]
- Alborali, L.; Bovo, G.; Lavazza, A.; Capellaro, H.; Guadagnini, P.F. Isolation of a herpesvirus in breeding catfish (Ictalurus melas). Bull. Eur. Assoc. Fish Pathol. 1996, 16, 134–137. [Google Scholar]
- Mugimba, K.K.; Byarugaba, D.K.; Mutoloki, S.; Evensen, Ø.; Munang’andu, H.M. Challenges and solutions to viral diseases of finfish in marine aquaculture. Pathogens 2021, 10, 673. [Google Scholar] [CrossRef] [PubMed]
- Roncarati, A.; Mordenti, O.; Stocchi, L.; Melotti, P. Comparison of growth performance of ‘Common Catfish Ameiurus melas, Rafinesque1820’, reared in pond and in recirculating aquaculture system. J. Aquacult. Res. Dev. 2014, 5, 218. [Google Scholar]
- Emmenegger, E.J.; Kurath, G. DNA vaccine protects ornamental koi (Cyprinus carpio koi) against North American spring viremia of carp virus. Vaccine 2008, 26, 6415–6421. [Google Scholar] [CrossRef] [PubMed]
- Fijan, N.; Petrinec, Z.; Stancl, Z. Vaccination of carp against spring viraemia: Comparison of intraperitoneal and peroral application of live virus to fish kept in ponds. Bull. Off. Int. Des Epizoot. 1977, 87, 441–442. [Google Scholar]
- Embregts, C.W.E.; Rigaudeau, D.; Veselý, T.; Pokorová, D.; Lorenzen, N.; Petit, J.; Houel, A.; Dauber, M.; Schütze, H.; Boudinot, P.; et al. Intramuscular DNA Vaccination of Juvenile Carp against Spring Viremia of Carp Virus Induces Full Protection and Establishes a Virus-Specific B and T Cell Response. Front. Immunol. 2017, 8, 1340. [Google Scholar] [CrossRef]
- Salem, H.M.; Ismael, E.; Shaalan, M. Evaluation of the effects of silver nanoparticles against experimentally induced necrotic enteritis in broiler chickens. Int. J. Nanomed. 2021, 16, 6783. [Google Scholar] [CrossRef]
- Yue, Z.; Teng, Y.; Liang, C.; Xie, X.; Xu, B.; Zhu, L.; Lei, Z.; He, J.; Liu, Z.; Jiang, Y.; et al. Development of a sensitive and quantitative assay for spring viremia of carp virus based on real-time RT-PCR. J. Virol. Methods 2008, 152, 43–48. [Google Scholar] [CrossRef]
- Goodwin, A.E.; Marecaux, E. Validation of a qPCR assay for the detection of Ictalurid herpesvirus-2 (IcHV-2) in fish tissues and cell culture supernatants. J. Fish Dis. 2010, 33, 341–346. [Google Scholar] [CrossRef]
- Souza, T.G.; Ciminelli, V.S.; Mohallem, N.D.S. A comparison of TEM and DLS methods to characterize size distribution of ceramic nanoparticles. J. Phys. Conf. Ser. 2016, 733, 6–11. [Google Scholar] [CrossRef]
- Farouk, M.M.; El-Molla, A.; Salib, F.A.; Soliman, Y.A.; Shaalan, M. The role of silver nanoparticles in a treatment approach for multidrug-resistant Salmonella species isolates. Int. J. Nanomed. 2020, 23, 6993–7011. [Google Scholar] [CrossRef]
- Galdiero, S.; Falanga, A.; Vitiello, M.; Cantisani, M.; Marra, V.; Galdiero, M. Silver nanoparticles as potential antiviral agents. Molecules 2011, 16, 8894–8918. [Google Scholar] [CrossRef] [PubMed]
- Lara, H.H.; Ixtepan-Turrent, L.; Garza-Treviño, E.N.; Rodriguez-Padilla, C. PVP-coated silver nanoparticles block the transmission of cell-free and cell-associated HIV-1 in human cervical culture. J. Nanobiotechnol. 2010, 8, 15–25. [Google Scholar] [CrossRef] [PubMed]
- Baram-Pinto, D.; Shukla, S.; Gedanken, A.; Sarid, R. Inhibition of HSV-1 attachment, entry, and cell-to-cell spread by functionalized multivalent gold nanoparticles. Small 2010, 6, 1044–1050. [Google Scholar] [CrossRef]
- Papp, I.; Sieben, C.; Ludwig, K.; Roskamp, M.; Böttcher, C.; Schlecht, S.; Herrmann, A.; Haag, R. Inhibition of influenza virus infection by multivalent sialic-acid-functionalized gold nanoparticles. Small 2010, 6, 2900–2906. [Google Scholar] [CrossRef]
- Speshock, J.L.; Murdock, R.C.; Braydich-Stolle, L.K.; Schrand, A.M.; Hussain, S.M. Interaction of silver nanoparticles with Tacaribe virus. J. Nanobiotechnol. 2010, 8, 19–27. [Google Scholar] [CrossRef] [PubMed]

| Target | Oligonucleotides | References |
|---|---|---|
| ECV major capsid protein gene | 5′-GTT CAT GAT GCG GAT AAT GTT GT-3′ 5′-ACC TCT ACT CTT ATG CCC TCA GC-3′ | [49] |
| SVCV glycoprotein gene | 5′-TGC TGT GTT GCT TGC ACT TAT YT-3′ 5′-TCA AAC KAA RGA CCG CAT TTC G-3′ | [58] |
| IcHV-2 DNA polymerase gene | 5′-ATA CAT CGG TCT CAC TCA AGA GG-3′ 5′-TAA TGG GTA TTG GTA CAA ATC TTC ATC-3′ | [59] |
| B-actin gene | 5′-CAA CAG GGA AAA GAT GAC GCA GAT-3′ 5′-GGG AGA GCA CAG CCT GGA T-3′ | this study |
| Concentration of AgNP (ng/mL) | Viability ± SEM (%) |
|---|---|
| 100 | 77.04 ± 1.70 * |
| 50 | 87.21 ± 2.55 * |
| 25 | 104.39 ± 2.21 |
| 12.5 | 99.77 ± 2.38 |
Disclaimer/Publisher’s Note: The statements, opinions and data contained in all publications are solely those of the individual author(s) and contributor(s) and not of MDPI and/or the editor(s). MDPI and/or the editor(s) disclaim responsibility for any injury to people or property resulting from any ideas, methods, instructions or products referred to in the content. |
© 2023 by the authors. Licensee MDPI, Basel, Switzerland. This article is an open access article distributed under the terms and conditions of the Creative Commons Attribution (CC BY) license (https://creativecommons.org/licenses/by/4.0/).
Share and Cite
Doszpoly, A.; Shaalan, M.; El-Matbouli, M. Silver Nanoparticles Proved to Be Efficient Antivirals In Vitro against Three Highly Pathogenic Fish Viruses. Viruses 2023, 15, 1689. https://doi.org/10.3390/v15081689
Doszpoly A, Shaalan M, El-Matbouli M. Silver Nanoparticles Proved to Be Efficient Antivirals In Vitro against Three Highly Pathogenic Fish Viruses. Viruses. 2023; 15(8):1689. https://doi.org/10.3390/v15081689
Chicago/Turabian StyleDoszpoly, Andor, Mohamed Shaalan, and Mansour El-Matbouli. 2023. "Silver Nanoparticles Proved to Be Efficient Antivirals In Vitro against Three Highly Pathogenic Fish Viruses" Viruses 15, no. 8: 1689. https://doi.org/10.3390/v15081689
APA StyleDoszpoly, A., Shaalan, M., & El-Matbouli, M. (2023). Silver Nanoparticles Proved to Be Efficient Antivirals In Vitro against Three Highly Pathogenic Fish Viruses. Viruses, 15(8), 1689. https://doi.org/10.3390/v15081689

